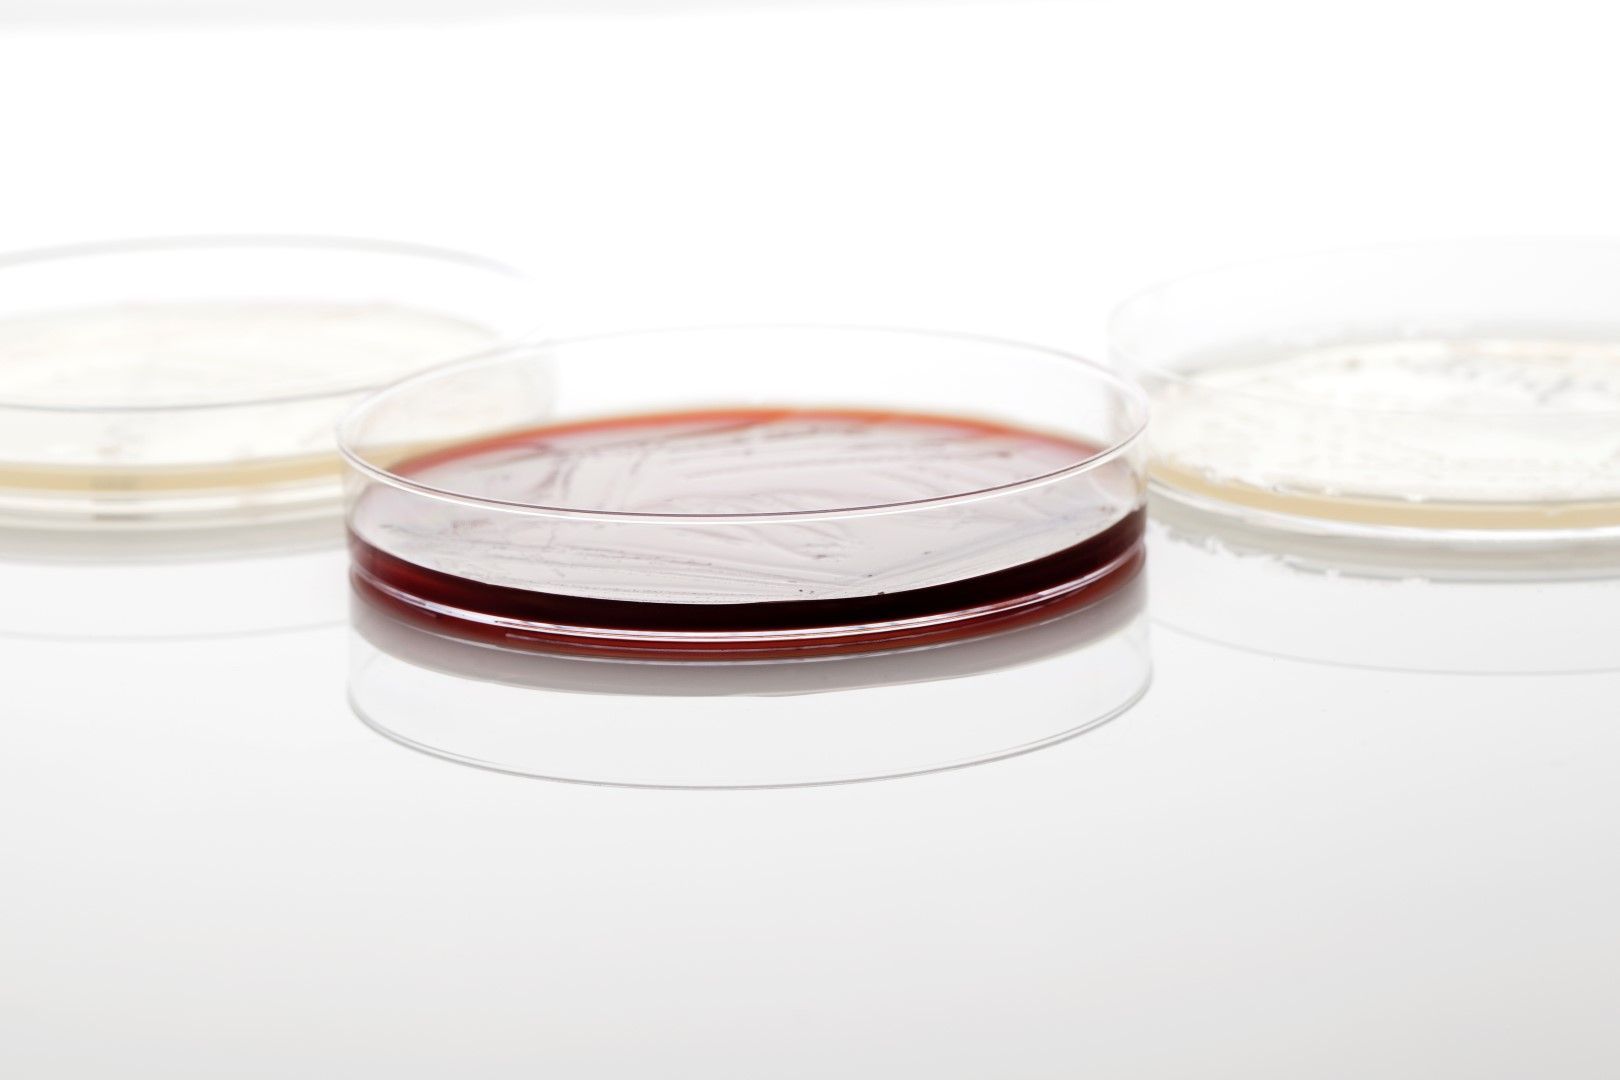
Microbial Identification Market Size 2021–2028

Microbial Identification Market Size 2021–2028
Microbial Identification Market 2021 Research Report is a professional and in-depth analysis of business trends and market growth which covers the past and present scenarios along with technological development. The report also highlights the major key players focusing on the latest development among the competitors. The report also includes market size, share, demand, estimation and forecast data.
This section of the microbial identification market report provides detailed data on the segments by analyzing them geographically, thereby assisting the strategist in identifying the target demographics for the respective product or service.
Request a FREE Sample Copy of Global Microbial Identification Market Report with Full TOC At: https://www.valuemarketresearch.com/contact/microbial-identification-market/download-sample
By Product & Service
· Instruments & Software
· Consumables
· Panels/ID Cards & Media
· Kits
· Other Consumables
· Services
By Technology
· Mass Spectrometry
· PCR
· Flow Cytometry
· Microscopy
· Other Microbial Identification Technologies
By End User
· Hospitals, Diagnostic Laboratories, and Blood Banks
· Pharmaceutical Companies & CROs
· Food Manufacturing Companies
· Beverage Manufacturing Companies
· Other
By Region
· North America
· Europe
· Asia Pacific
· Latin America
· Middle East and Africa
Browse Full Global Microbial Identification Market Research Report With TOC At: https://www.valuemarketresearch.com/report/microbial-identification-market
The research report also covers the comprehensive profiles of the key players in the market and an in-depth view of the competitive landscape worldwide. The major players in the report are Becton Dickinson and Co., Bruker Corp, Charles River Laboratories Inc, bioMerieux SA, Hy laboratories Ltd., Sigma-Aldrich Corp. Siemens Healthcare and Thermo Fisher Scientific Inc. This section includes a holistic view of the competitive landscape that includes various strategic developments such as key mergers & acquisitions, future capacities, partnerships, financial overviews, collaborations, new product developments, new product launches, and other developments.
This section covers regional segmentation which accentuates on current and future demand for microbial identification market across North America, Europe, Asia-Pacific, Latin America, and Middle East & Africa. Further, the report focuses on demand for individual application segment across all the prominent regions.
Purchase complete Global Microbial Identification Market Research Report At: https://www.valuemarketresearch.com/contact/microbial-identification-market/buy-now
About Us:
Value Market Research was established with the vision to ease decision making and empower the strategists by providing them with holistic market information.
We facilitate clients with syndicate research reports and customized research reports on 25+ industries with global as well as regional coverage.
Contact:
Value Market Research
401/402, TFM, Nagras Road, Aundh, Pune-7.
Maharashtra, INDIA.
Tel: +1-888-294-1147
Email: sales@valuemarketresearch.com
Website: https://www.valuemarketresearch.com
VMR News: https://www.vmrnews.com
Appreciate the creator